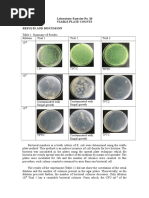

Vanessa Olga Dagondon
Date Performed:10/06/16
Isabel Palmitos
Date Submitted: 10/17/16
Experiment No. 7
THIN LAYER CHROMATOGRAPHY OF LIPID EXTRACTS
I.
INTRODUCTION
Lipids are biomolecules that is insoluble or sparingly insoluble in water but soluble
in nonpolar organic solvents. Lipids vary widely on their molecular shapes and size.
However, they do not have a common structural figure that would serve as a basis for
defining them. The only thing lipids have in common is their insolubility in water
(Stoker, 2013).
Lipids serve as a major energy source in the body. They play different functions in
the body such as providing a hydrophobic barrier that permits partitioning of the aqueous
contents of the cells and subcellular structures or maintaining the bodys homeostasis. A
disruption on the bodys lipid metabolism may cause some major clinical problems such
as atherosclerosis and obesity (Harvey & Ferrier, 2011).
Lipids can be classified according to their biochemical function or according to their
ability to break down into smaller units through basic hydrolysis (Stoker, 2013).
Based on biochemical function, lipids can be grouped into five,
(1) Energy-storage lipids (triacylglycerols)
(2) Membrane lipids (phospholipids, sphingoglycolipids, and cholesterol)
(3) Emulsification lipids (bile acids)
1
(4)Messenger lipids (steroid hormones and eicosanoids)
(5)Protective-coating lipids (biological waxes)
�On the other hand, based its ability to saponify when it undergoes basic
hydrolysis, lipids can be divided as,
(1) Saponifiable lipids (triacylglycerols, phospholipids, sphingoglycolipids, and
biological waxes)
(2) Nonsaponifiable lipids (cholesterol, steroid hormones, bile acids, and
eicosanoids)
Saponifiable lipids are those that is hydrolysable by heat and alkali while
nonsaponifiable lipids are not.
Isolation of lipids can be done by using different solvent systems. Two wellknown solvent system for lipid extraction is the Folch and the Bloor solvent system.
Folch solvent system consist of chloroform: methanol with a ratio 2:1 while Bloor uses
ethanol-ether that has a ratio of (3:1). In order to purify and separate lipid classes, special
washes are done with the extracts. Extra care must be considered in extracting lipids
since they can easily be oxidized or polymerized. One most convenient separation
technique for lipids extract is through chromatographic procedure.
TLC or thin layer chromatography is a type of planar chromatography that is
considered to be an extremely valuable technique in the laboratory. It provides a rapid
separation of compounds that gives an indication of the number and nature of the
components of the mixture. It is also used to identify compounds by comparison with
standard samples (Christian, 2004).
In TLC, separation of mixture is done by allowing a nonpolar (lipophilic) solvent
2
travel upward the plate. The solvent migrate upward the plate through capillary action,
carrying the sample mixture along with it. The extent to which the mixtures components
�move along the plate is dependent on their relative affinity to the moving phase (solvent)
and the stationary phase (adsorbent). Thus, TLC separation is dependent on the
differences in partition coefficients. The ratio of the distance a compound moves to the
distant the solvent moves is the Rf value or retention factor. This value is characteristic
of the compound, the solvent, and the stationary phase (Christian, 2004).
Rf
dist . traveled by analyte
dist . traveled by solvent
By the end of the experiment, students should be able to,
(1) Be able to extract lipids from different samples, and
(2) Semi-quantitatively and qualitatively identify lipid compositions of the
samples through the use of TLC.
II. METHODOLOGY
Extraction of Lipid Samples
Egg yolk, milk, butter, and chicken skin were used as samples for lipid extraction.
Approximately 1.0g of each solid sample (egg yolk, butter, chicken skin) was weighed
and was placed into a 15mL test tube. 5.0mL ethanol:ether (3:1 v/v) was added into the
tube and the solution was centrifuged for about 15 minutes. The nonpolar extract of each
sample was obtained and was used for the thin layer separation.
For the milk sample, 10mL of evaporated milk was centrifuged for 15 minutes. The
separated fat, found as a firm layer on the surface of the skim milk, was transferred into a
different test tube and was added with 2.0mL of ethanol:ether (3:1 v/v). Upon addition,
the
3 solution was stirred using a stirring rod. The lipids would dissolve and a non-lipid
residue would be observed. The nonpolar extract was used for the TLC.
-
�Thin Layer Chromatography of Extracted Lipids
Commercially available silica plate was provided by the laboratory stockroom.
Using a pencil and a ruler, seven small dots were drawn in the plate approximately 0.9cm
from the edge of the plate. The dots served as a guide during the spotting of the standards
and samples. Standard lipid markers (oleic, -lectin, cholesterol) and samples were
spotted into the TLC plate three times (allowing each spot to dry every time) using fine
capillary tubes.
The TLC plate was placed inside a chamber containing a solvent system of
petroleum ether: diethyl ether: glacial acetic acid ([Link] v/v/v). The chamber was
equilibrated with the same solvent system before use. When the solvent has almost
reached to top of the plate, the TLC was removed from the chamber and was allowed to
dry.
After drying, the plate was placed inside another chamber containing iodine vapor.
Once the marks are visible, it was traced with a pencil in order to mark the location of
the lipids since it disappears quickly.
III. RESULTS AND DISCUSSION
Thin Layer Chromatography (TLC) was used in attempt to separate the lipid components
of the samples, egg yolk, milk,margarine and chicken skin. The standards used are Oleic
acid, - lecithin and cholesterol. These standards, together with the lipid extracts of the
samples, were spotted onto a TLC plate coated with a polar adsorbent, silica and was
developed in a chamber containing the solvent system, petroleum ether: diethyl ether:
4
glacial acetic acid ([Link] v/v/v). The resulting chromatogram, after exposing to the
visualization agent, iodine vapor, is shown in figure 1.
�Oleic acid - lecithin cholesterol milk margarine egg yolk chicken skin
Figure 1. Chromatogram
The separated lipids on the chromatogram were marked with a pencil and their
corresponding Rf values were calculated. The Rf values for the standards and the lipid
extract samples are presented in Tables 1 and 2, respectively. Also Table 2 shows the
identity of the separated lipid extracts.
Table 1. Rf values of lipid standards
Standard Lipids
Distance traveled
Distance traveled
Rf
Oleic acid
- lecithin
Cholesterol
by the sample, cm
0.70
2.05
0.35
by the solvent
5.9
5.9
5.9
0.12
0.35
0.06
Table 2. Lipid composition of lipid extracts from different sample
Sample
Distance
Distance
Rf
Identity
�Egg yolk
Milk
Margarine
Chicken skin
traveled by the
traveled by the
sample, cm
2.1
4.1
2.2
2.2
4.7
solvent, cm
5.9
5.9
5.9
5.9
5.9
0.36
0.69
0.37
0.37
0.80
- lectin
Cholesterol
- lectin
- lectin
Cholesterol
Before separating the samples into its components using TLC, the samples were first
extracted using ethanol:ether (3:1 v/v) solvent system introduced by Bloor. The goal of
the extraction lipids is to separate cellular or fluid lipids from other constituents such as
proteins, polysaccharides, small molecules (amino acids, etc.) and at the same time,
preserve the lipids for TLC analysis.
TLC separation brought by the affinity of the samples in the stationary phase and mobile
phase. In this case, the stationary phase is the silica embedded on the TLC plate and the
mobile phase is the solvent system, petroleum ether: diethyl ether: glacial acetic acid
([Link] v/v/v). Silica is very polar stationary phase as shown in its structure in Figure 2.
Figure 2. Structure of Silica: The positive
character of the silicon and the negative
character of the oxygen make silica a polar
stationary phase.
The mobile phase, on the other hand, is a mixture of organic solvents. The choice for the
6
mobile
phase is crucial in the separation of the lipids; it is co-dependent on the structure
of the analyte.
�In order for the separation to take place, the mobile phase must flow past the stationary
phase. This is why the plate was only removed from the chromatographic chamber when
the solvent reached the top of the plate. Basically, what happens here is that the lipid
components of the sample are drawn into the stationary phase or the mobile phase
depending on their affinity on the phases, causing a difference in the distance they travel
in the plate. This affinity is based on the old adage, like-dissolves-like; polar molecules
will have a higher affinity in the more polar stationary phase while the non-polar
molecules will have a lower affinity for the stationary phase and will tend to remain in
the solvent longer. In this case, the more polar the component lipid in the extract is, the
shorter is the distance traveled of that particular component in the plate; the polar
functional group in that lipid component tends to interact more with the polar stationary
phase causing it to move slower in the plate. Likewise, the less polar the component lipid
is, the longer is the distance that it will travel in the plate; the less polar the functional
group interacts more with the mobile phase causing it to move faster in the plate. The
standards used are oleic acid (Figure 3a), - lecithin (Figure 3b) and cholesterol (Figure
3c).
(a)
(b)
7
�(c)
Figure 3. Structures of the standards used: (a) Oleic acid, (b) - lecithin, (c) cholesterol
Oleic acid is a monosaturated omega-9 fatty acid which naturally occurs in some animals
and vegetable fats and oils. Fatty acids like oleic acid occur as their esters also known as
triacylglycerols. Triacylglycerols are composed a glycerol backbone esterified with 3
fatty acids. Another class of lipid is phospholipids. It is similar to that of triacylglycerols
except the a carbon (C3) of the gycerol backbone is esterified to phosphoric acid.
Phosphatidic acid is the building blocks of phospholipids. Substitutions, such as choline,
can produce phosphatidylcholines also called as lecithin. The third class of lipids is
sterols which includes cholesterol and does not contain any fatty acids unlike
phospholipids and triacylglycerols which make them non-saponifiable. Based on their
structures, phospholipids are the most polar among the classes of lipids mentioned,
followed by triacylglycerols and sterols. This means that it is expected for the lecithin to
have the shortest distance traveled and also, the lowest Rf value, followed by oleic acid
and finally, by cholesterol. However, according to the Rf values obtained, the reverse is
shown. This makes the whole data erroneous. This could be explained by experimental
errors such not having enough time for development in the chromatographic chamber
8
and by not exposing the chromatogram enough to the visualizing agent, Iodine vapor,
especially since the main draw back in using iodine vapor is that it only detects double
�bonds, not single bonds, or maybe an error from obtaining the lipid extract by
centrifugation.
The
samples
were
analyzed
are
the
following:
(1) egg yolk: Egg yolk is composed of 31% of lipids. In this 31%, 65% is neutral lipids
which are the triacylglycerols, 30% is phospholipids, and 5% is cholesterol. The bands
showing an Rf values of 0.36 and 0.69 may represent oleic acid and cholesterol,
respectively.
(2) Milk: Milk is composed of 95-96 % triglycerides while sterols such as cholesterol
constitute 0.2-0.4% of the total lipid content of milk. The band showing an Rf
value of 0.37 may represent low molecular fatty acids.
(3) Margarine: Margarine is derived from a combination of plant oils, animal fat and
some milk constituents. In contrast, butter is made from milk fat. Margarine
contains 80% of fat, 10-20% of which is saturated fatty acids,and relatively high
amounts of unsaturated fatty acids. Plant-based margarine has no cholesterol. The
band showing an Rf value of 0.37 may represent low molecular fatty acids.
(4) Chicken skin: Chicken skin is composed of 75% lipids, 30% of which is saturated
fatty acids, 62% is unsaturated fatty acids, and the rest are cholesterol,
phospholipids and fatty acid derivatives. The band with Rf value of 0.80
represents cholesterol.
�IV. CONCLUSION
Lipids are biomolecules are insoluble in water but are soluble in organic solvents. They
play a vital role in the body as a major source of energy and as a hydrophobic barrier that
maintains the bodys homeostasis. Lipids are classified according to their biological
functions and their ability to saponify. In this experiment, lipids from different sources
are extracted and separated using Thin layer chromatography (TLC). TLC provides a
rapid separation of compounds based on their affinity to the mobile and stationary phase.
Furthermore, these compounds can be identified by comparison with standard samples.
In the experiment, lipids were extracted from egg yolk, milk, margarine and chicken skin
using ethanol-ether solvent system. These lipid extracts were separated and identified
using TLC with silica embedded on the TLC plate as the polar stationary phase
petroleum ether: diethyl ether: glacial acetic acid ([Link] v/v/v) as the non-polar mobile
phase. In theory, a polar compound to be separated will travel the shortest distance
because it would have a higher affinity for the polar stationary phase, while the less polar
compounds will travel the longest distance. This can described quantitatively using Rf
values. The standards used were oleic acid, a fatty acid which usually occurs in the
saponifiable lipids known as triacylglycerols; - lecithin, a phospholipid similar to that
of triacylglycerols except the a carbon (C3) of the gycerol backbone is esterified to
phosphoric acid; and, cholesterol which is a sterol, a non-saponifable lipid. These
standards can be arranged in increasing polarity: sterols, triacylglycerols, phospholipids.
Thus, it is expected for the lecithin to have the shortest distance traveled and also, the
10
lowest Rf value, followed by oleic acid and finally, by cholesterol. Iodine vapor was used
as the visualizing agent to enhance the separated bands in the developed chromatogram.
�The lipid extracts of the sample showed the following results: for the egg yolk, bands
showed an Rf values of 0.36 and 0.69 which may represent triacylglycerols and sterols,
respectively; for milk, a band showed an Rf value of 0.37 which may represent low
molecular fatty acids; for margarine, a band showed an Rf value of 0.37 which may
represent low molecular fatty acids; and for chicken skin, a band with an Rf value of 0.80
represents cholesterol.
V. REFERENCES
Akoh, C. C., & Min, D. B. (1998). Food lipids: Chemistry, nutrition, and biotechnology.
New York: Marcel Dekker.
Thin
Layer
Chromatography.
(n.d.).
Retrieved
October
16,
2016,
from
[Link]
Holtzhauer, M. (2006). Basic methods for the biochemical lab. Berlin: Springer.
Steroids - Boundless Open Textbook. (n.d.). Retrieved October 16, 2016, from
[Link]
Havery, R., Ferrier, D. (2011). Lippincotts Illustrated Reviews: Biochemistry Fifth
Edition. Wolters, Kluwer | Lippincott Williams & Wilkins.
Stoker, H. (2013). General, Organic, and Biological Chemistry. Brooks/Cole, Cengage
Learning.
Christian, G. (2004). Analytical Chemistry Sixth Edition. John Wiley & Sons, Inc.
11
�VI. APPENDIX
Calculation of Rf values:
Rf
dist . traveled by analyte
dist . traveled by solvent
*Oleic acid:
Rf
* - lecithin:
*Cholesterol:
*Milk:
Rf
*Margarine:
0.70cm
0.12
5.9cm
Rf
2.05cm
0.35
5.9cm
Rf
0.35cm
0.06
5.9cm
2.2cm
0.37
5.9cm
Rf
2.2cm
0.37
5.9cm
4.1cm
0.69
5.9cm
2.1cm
Rf
0.36
5.9cm
*Egg yolk:
Rf
*Chicken skin:
12
Rf
4.7cm
0.80
5.9cm